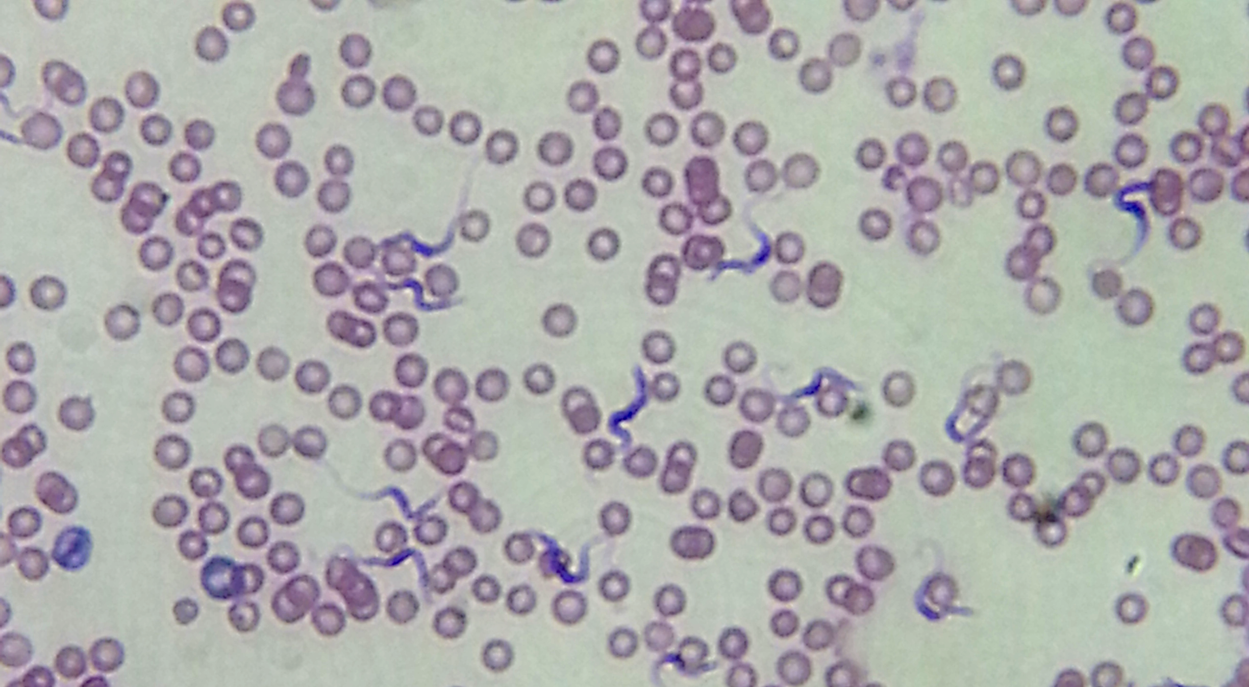

Are protists monophyletic or PARAphyletic?
PARAPHYLETIC
What are the supergroups of protists studied in this lab, the clades covered, and the examples covered?
Excavata (crystalline rod)
- Euglenozoans
- Kinetoplastids
- Euglenids
SAR (smooth and hairy flagella, 2 different)
- Stramenophile
- Diatoms
- Brown algae
- Alveolates (have aleoli)
- Ciliates
- Dinoflagellates
- Apicomplexan
- Rhizarians (have pseudopodia)
- Foraminiferans
- Radiolarians
What are mixotrophs, heterotrophs, and autotrophs?
autotrophs - photosynthesize and cehmosynthesis
heterotrophs - ingest organic molecules
mixotrophs - both auto and hetero
Describe Excavata
Have long flagella supported by crystalline rod.
What supergroup and clade are trypanosoma a part of? What defines these?
Kinetoplastids which are euglenozoans and are excavata.
These have a single large mitochondrion with an organized mass of DNA (kinetoplast)
Trypanosoma brucei causes what disease? How is it transmitted?
African sleeping sickness
transmitted by the tsetse fly.
What defines a euglenid? What clade and supergroup are these in?
Euglenozoan and excavata
Defined by pigmented eyespot next to light detector

What clade and supergroup are diatoms a part of? What is a defining characteristic?
These are stramenophile in clade and are in the supergroup SAR clade
Defined by two-part glass-like wall of hydrated silica, have flagella as gametes but lose when mature
When they die their silica walls are mined to make diatomaceous earth

What clade and supergroup are brown algae in? What are some defining characteristics?
Stramenophile and SAR clade
Pigment is fucoxanthin, algin used as emulsifying agent, most complex multicellular anatomy of all algae.

What clade and supergroup are ciliates in? special characteristic?
Alveolates and SAR clade
Have micro and macro nucleus, move with short and numerous cilia, have oral groove

What are a common characteristic to dinoflagellates? What do they cause when they proliferate quickly in water? ARe they photo or heterotrophs? What clade and supergroup?
Alveolates
BOTH PHOTOAUTO AND HETERO
Cause red tide
all have two flagella, spin in water, circumferential groove.

What clade and supergroup are apicomplexans a part of? What is a human disease they cause and the organism that causes it? What is a common characteristic?
Alveolate and SAR clade
Malaria by plasmodium
All have apical complex that functions in penetration of host cell.

What is the common characteristic to Rhizaria?
have pseudopodia
What clade and supergroup are foraminifera in? What is a common characteristic?
Rhizarians and SAR clade
reticulopodia emerge from shell pores to form dense networks. calcium carbonate shell.

What clade and supergroup are radiolorians in? What are some common characteristics?
Rhizarian and SAR clade
axopodia - pseudopodia reinforced by radiating mircotubules, MAILS SPHERICAL, endoskeleton of silica



